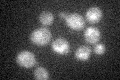
YPL156C
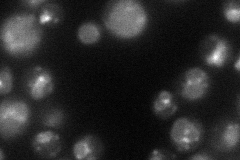
YPL156C
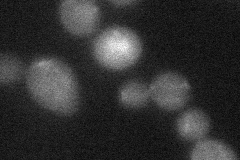
YPL156C

View description
Pheromone-regulated protein proposed to be involved in mating; predicted to have 1 transmembrane segment; transcriptionally regulated by Ste12p during mating and by Cat8p during the diauxic shift
Localization:
Intensity:
Fold change:
Significance:
-
C’ GFP library in SD
punctate18.04 -
N' NOP1pr-GFP in SD
vacuole membrane46.0866 -
N' TEF2pr-mCherry in SD

vacuole53.9453 -
N' NATIVEpr-GFP in SD

below threshold22.988 -
N' TEF2pr-VC and Cyto-VN in SD
below threshold25.4229 -
C’ GFP library in SD+DTT

punctate19.441.07No -
C’ GFP library in SD+H2O2

punctate14.80.82No -
C’ GFP library in Starvation Media

punctate26.151.44No -
C’ GFP library on the background of Pup2-DaMP

punctate -
C’ GFP library on the background of CCT mutant

punctate16.51920.915389No
